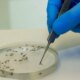
brasil-vai-ampliar-uso-da-bacteria-wolbachia-no-combate-a-dengue

O Instituto de Biologia Molecular do Paraná (IBMP) e o World Mosquito Program (WMP) inauguraram neste sábado (19) a Wolbito do Brasil, maior biofábrica do mundo especializada...

Seis municípios devem receber em julho as primeiras solturas de mosquitos Aedes aegypti infectados com a bactéria wolbachia: Uberlândia em Minas Gerais; Londrina e Foz do...